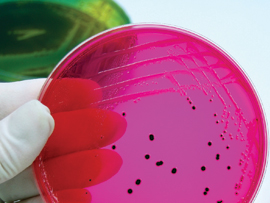
Ec1106 54 Lead

Fecal coliform transport on agricultural land can vary greatly with precipitation, livestock densities, and other environmental considerations. Various studies have discussed the effectiveness of different conservation practices for reducing fecal coliform loads on streams and subsurface water. These studies all conclude that grass buffers, along with other support practices, can result in significant load reductions. These studies also indicate that bacteria can be tied to soil particles and that soil erosion practices can also aid in reducing fecal coliform loads. This article reviews several research publications regarding the transport of bacteria in waterways and through different types of buffer systems, impacts from the lack of buffers, and overall contributions from agriculture to surface and subsurface waterways.
Fecal coliform bacteria are often declared to be an impairment requiring total maximum daily loads (TMDLs) in watersheds with heavy agricultural land use. Fecal coliform is often utilized as an indicator according to land use of livestock presence in or near waterways or presence of failing onsite sewage treatment facilities. In order to plan for best management practices (BMPs) that will address these issues, one must first understand the organism and how it reaches our waterways.
Fecal coliform bacteria are classified in the group proteobacteria and characterized as a chemoheterotropic proteobacteria. This includes the enteric bacteria, which inhabits the intestinal tract of animals; most enteric are rod-shaped facultative anaerobes; many are usually harmless; others are generally pathogenic, including Salmonella, one of the microorganisms that cause food poisoning. These bacteria absorb their nutrients from the body fluids of living hosts and will use oxygen if it is present but can also grow by fermentation in an anaerobic environment.
Fecal coliform transport through soils is affected by several factors: presence or absence of livestock, the amount of soil water available to transport fecal bacteria to the conduit waters, the storage of fecal bacteria in the soil zone, and the rate of bacterial die-off in percolation and conduit waters. It has been shown that fecal bacteria have rapid die-off rates in natural waters, with a half-life on the order of one day or less (Pasquarell and Boyer 1994). On the other hand, microorganisms that remain in the soil aerobic zone may survive for prolonged periods of time, perhaps on the order of several months. Peak fecal bacteria concentrations have been shown to coincide with peak flow and peak sediment load in karst springs, indicating that soil attachment is an important mode of transport (Boyer and Kuczynska 2003).
Various studies have been conducted to determine the effectiveness of conservation practices’ abilities to reduce fecal coliform contamination from agriculture lands. One particular study reported by Boyer in 2008 indicated a reduction of 85% to 96% of fecal coliform concentrations in excluded sinkholes located in pastureland. It was shown to be an effective practice for reducing fecal coliforms. Another more experimental study provided evidence that fecal coliform reduction can be approximately 99% in buffers as little as 1 meter. This study utilized simulated rainfall events and manure applications (Sullivan et al. 2007). Impacts of grazing systems were observed by Sovell et al. in 2000, and it was concluded that only fecal coliform and turbidity would show significant differences between buffer types. The study demonstrated that grass buffers were more effective than forested buffers due to their additional ground cover. It even demonstrated that grazed buffers in a rotational grazing system where the buffers themselves are grazed periodically can reduce loads by 40% compared to continuously grazed systems where there is no buffer between the grazing unit and the waterway.
In 1999, Boyer described a study conducted in the Greenbrier Valley of West Virginia, comparing two dairy operations. One operation had no BMPs to control fecal contamination; the other operation included a waste storage facility to address fecal-contaminated runoff. Evaluation of sampling data from this study indicated that there was a 99% difference between the fecal counts associated with the two operations. The dairy with the waste storage facility contributed less. Additionally, samples for this study were also taken along pastureland with no BMPs to control animal waste. The study concluded that such BMPs as rotational grazing, division fencing, animal exclusion from sinkholes, and water distribution systems for livestock are adequate for reducing fecal coliform densities. A waste management system with such practices as roofing and curbing of the loafing pad, a waste storage structure, and a manure and nutrient management plan can reduce the potential for affecting water quality. Additionally, in the same area, another study compared storm and seasonal distributions of fecal coliform and cryptosporidium in a spring; fecal coliform densities did not correlate positively with Cryptosporidium oocyst densities. Fecal coliform densities were greatest at storm peaks, when sediment loads were also greatest (Boyer and Kuczynska 2003).
Preliminary results indicating that fecal coliform transport in waterways is a mechanism of sedimentation has also been seen in a study being conducted along Milligan Creek in the Greenbrier Valley of West Virginia. At five sites along this stream, water samples were taken two different ways and analyzed for fecal coliform counts and turbidity (Table 1). The first sample at each site was taken at normal water flow and turbidity. The second sample at each site was altered. Sediment from the bottom of the stream was kicked up into suspension while the sample was being taken. The purpose of this experiment was to determine if sediment could be the source of bacterial contamination in this stream. In all five samples, a significant increase in turbidity demonstrated a significant increase in fecal coliform counts for that site, consistent with the findings of Boyer and Kuczynska in 2003. While Milligan Creek is a large karst window that sinks and rises several times, it can be speculated that one bacteria source for the stream is sediment being flushed out of the cave system that feeds the creek.
Fecal coliform can also be transported through soil without becoming tied up by soil particles. Studies have also shown that fecal coliform bacteria can be transported directly through soil strata in times of heavy rain events. In fact, Guber et al. indicated in 2005 that enhanced bacterial transport may happen in soil with well-developed macropore system as a result of intensive rainfall in a short period after manure application. Macropores have equivalent diameters d>30μ. They provide the main drainage pathway during heavy rainfall events. These pathogens can become entrapped in the macropores, clogging them and altering their pore geometry (Buchan and Flury 2004). This is further evidence that bacteria can become tied up by the soil system and that erosion prevention practices can be an effective measure in reducing the overall fecal coliform load of a watershed.
Soupir in 2006 reported on a study that concluded that grass filter strips were not as effective at removing bacteria as they are at removing sediment. The study continues to say that practices that reduce the first-flush effects, such as detention basins, could more effectively reduce bacteria transport. These practices reduce water flow and allow it to infiltrate into the soil before it reaches surface waterways.
Discussion
The referenced studies all indicate that fecal coliform bacteria can be significantly reduced by implementing BMPs. In all instances the BMP that accomplishes this is a vegetative grass buffer or filter strip and additional support practices that work with the buffer in a conservation system, such as a livestock watering system or a detention basin. The BMP works by reducing water velocity of overland flow, capturing bacteria-laden sediment and allowing stormwater to infiltrate into the soil before it can reach a surface water conduit. While one study indicates that this can be accomplished with as little as a 1-meter-wide buffer, a more in-depth study indicates that on slopes of 2% to 20%, a 6-meter buffer is usually adequate to accomplish this goal (Hook 2003). These studies also indicate that, depending on the overall load in the watershed, there should be a correlation between bacteria counts and stream turbidity, because bacteria levels increase with peak flow and turbidity. This correlation could only be calculated on an individual watershed basis and would require soil, water, and sediment analysis to determine the actual load associated with the watershed.
Another important factor in the development of an agricultural system to address bacteria loads is the implementation of support practices. Such practices as alternative watering systems, grazing systems, and walkways prevent pressure on a buffer or the area near the buffer. Livestock are then forced to distribute manure throughout the grazing area when watering occurs at areas farther away, when they walk through nonsensitive areas, or when they loaf in areas with reduced runoff. In fact, the EPA-approved Watershed Based Plan for Second Creek in West Virginia references the Chesapeake Bay Model, which indicates a 90% load reduction by implementing a rotational grazing system in conjunction with an offsite watering system (Burns 2009). This is a 50% increase in load reduction over what was reported by Sovell in 2000 for rotational grazing systems over a continuous grazing in which the riparian area is grazed in both situations.
Conclusion
Fecal coliform bacteria are transported primarily by being tied to sediment, which is washed into waterways through erosion. To manage land and reduce contamination, the following factors should be considered:
- Implement BMPs that reduce first-flush effects by slowing stormwater velocity and allowing sediment to fall out of suppression into a vegetated area before it reaches a waterway. Such BMPs could include detention basins, water bars, sodding, terracing, diversions, and vegetative buffers.
- Where possible, develop BMPs that allow stormwater to infiltrate into soil strata and only reach waterways by subliminal flow. Such BMPs could include infiltration basins (rain gardens), compost sponge, sub-soiling, and vegetative buffers. These practices should also be maintained frequently, depending on the overall bacteria load, to prevent clogging of micropores.
- Buffer widths should be determined on a case-by-case basis with several considerations: (1) Consider the area it is buffering; what will be the sediment and stormwater discharge load the buffer will need to address? (2) Consider the environmental considerations; what is the rainfall, slope, and other runoff factors for both the buffer itself and the area it is buffering as well as additional stresses on the buffer? (3) What other support management practices can be installed to prevent stress and additional load on the buffer? The final buffer width should be adequate to prevent any overland flow from reaching the waterway, and allow the majority if not all sediment to fall out in the vegetative area.
- Develop grazing systems that force livestock to spread their manure throughout the grazing unit to prevent concentrated manure in one area. Concentrated manure combined with trampled vegetation and compacted soils from heavy livestock use create an area prime for mass erosion during heavy rain events.
- On karst topography, prevent eroded material and contaminated stormwater from reaching open sinkholes. The cave environment is conducive to bacteria viability and will allow it to be flushed out into a surface waterway over time.
- While implementing BMPs that aid in reducing the overall load on a watershed, it may take a considerable amount of time for the stream to show reductions, depending on how much bacteria-laden sediment is built up in the streambed or cave system. In the short term, overall load reductions can be estimated as shown in Table 2 if the overall load has been determined.
- When possible, if the goal of a conservation plan is to address fecal coliform loads of a watershed, plans should be developed to the resource management system level to achieve the maximum possible load reduction. A resource management system addresses all natural resources concerns that pertain to plants, soil, water, animals, and air (NRCS Field Office Technical Guide).